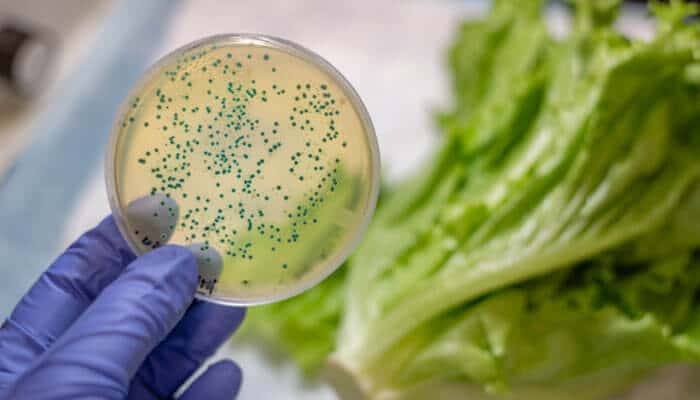

When a wave of E. coli outbreaks sweeps across the nation, the ensuing legal battles can become complicated and far-reaching. From diners to farmers, and fast-food chains to food processing companies, no part of the food supply chain is immune to the ramifications of an outbreak. Understanding who is liable, the extent of the damages, and which legal paths are available for those affected by contamination is essential. Below, we delve into the intricate relationship between E. coli infections and the legal system, providing insight into what survivors of such outbreaks face in the aftermath. Keep reading to learn more about the legal complexities surrounding these health crises.
Understanding the Legal Implications of E. Coli Outbreaks
E. coli outbreaks not only pose significant health risks but also have complex legal implications. Victims may face extensive medical bills, lost wages, and enduring trauma. Legal cases can hinge on proving negligence on the part of food producers, processors, distributors, or retailers in maintaining safety standards. The challenge often lies in tracing the contamination back to its source, which requires meticulous investigation and expert testimonies.
The entities within the supply chain responsible for an E. coli outbreak are legally obligated to comply with a myriad of safety regulations. Failure to adhere to these standards can result in stringent penalties, including product recalls, fines, and closures. However, proving liability can be a contentious process, as companies often employ robust legal teams to protect their interests.
For those affected by e. coli outbreaks, the road to legal recourse is both emotionally and financially taxing. Class action lawsuits can provide an avenue for victims to pool resources and have their cases heard en masse. These actions can lead to significant settlements or jury awards, providing some measure of recompense to the victims.
The Role of Food Safety Regulations in Preventing E. Coli Contamination
Food safety regulations play a critical role in preventing E. coli contamination. Agencies such as the Food and Drug Administration (FDA) and the United States Department of Agriculture (USDA) set and enforce standards designed to mitigate the risk of foodborne illnesses. These regulations encompass everything from farm-level controls to processing, packaging, and distribution safeguards.
Despite stringent regulations, E. coli outbreaks continue to happen. This raises important questions about the efficacy of current food safety measures and their enforcement. In some instances, producers may lack the necessary resources to implement required controls, while in others, the swift nature of the supply chain allows for lapses in safety checks.
When new outbreaks occur, regulatory agencies often respond by strengthening guidelines and ramping up inspection frequencies. However, these changes come too late for those already affected by E. coli. As such, preventing contamination remains both a priority for public health officials and a challenge for the industry.
Impact of E. Coli Outbreaks on the Food Industry and Supply Chain
E. coli outbreaks can have a profound impact on the food industry, affecting consumer trust, corporate reputations, and overall financial stability. Manufacturers and retailers might see a decline in sales, particularly of the products linked to an outbreak. This often results in a concerted effort within the industry to reinforce food safety practices and regain public confidence.
Supply chains are equally impacted, as contamination can lead to widespread product recalls and the destruction of contaminated goods. This can disrupt operations and impose heavy financial losses on companies. In recent years, traceability has become a pivotal focus, with industry leaders investing in technologies to track food products from farm to table more effectively.
Recent E. Coli Outbreak Cases and Their Legal Outcomes
In recent years, E. coli outbreaks have led to several high-profile legal cases. Fast food chains, salad suppliers, and even organic food companies have found themselves embroiled in litigation. These cases frequently become the focal point in media coverage, casting a spotlight on the implicated businesses and the regulatory framework supposedly in place to prevent such occurrences.
The legal outcomes of these cases can set precedents for future litigation and have wider implications for food safety regulation. Settlements often include not only financial compensation for those affected but also stipulations for the companies involved to modify their practices and prevent further incidents.
Overall, the legal ramifications of E. coli outbreaks underline the necessity for robust food safety systems and the critical role of proactive regulatory enforcement. As the food industry evolves, it remains incumbent upon all stakeholders to safeguard public health and work collectively to mitigate legal risks and ensure the integrity of our food supply chain.